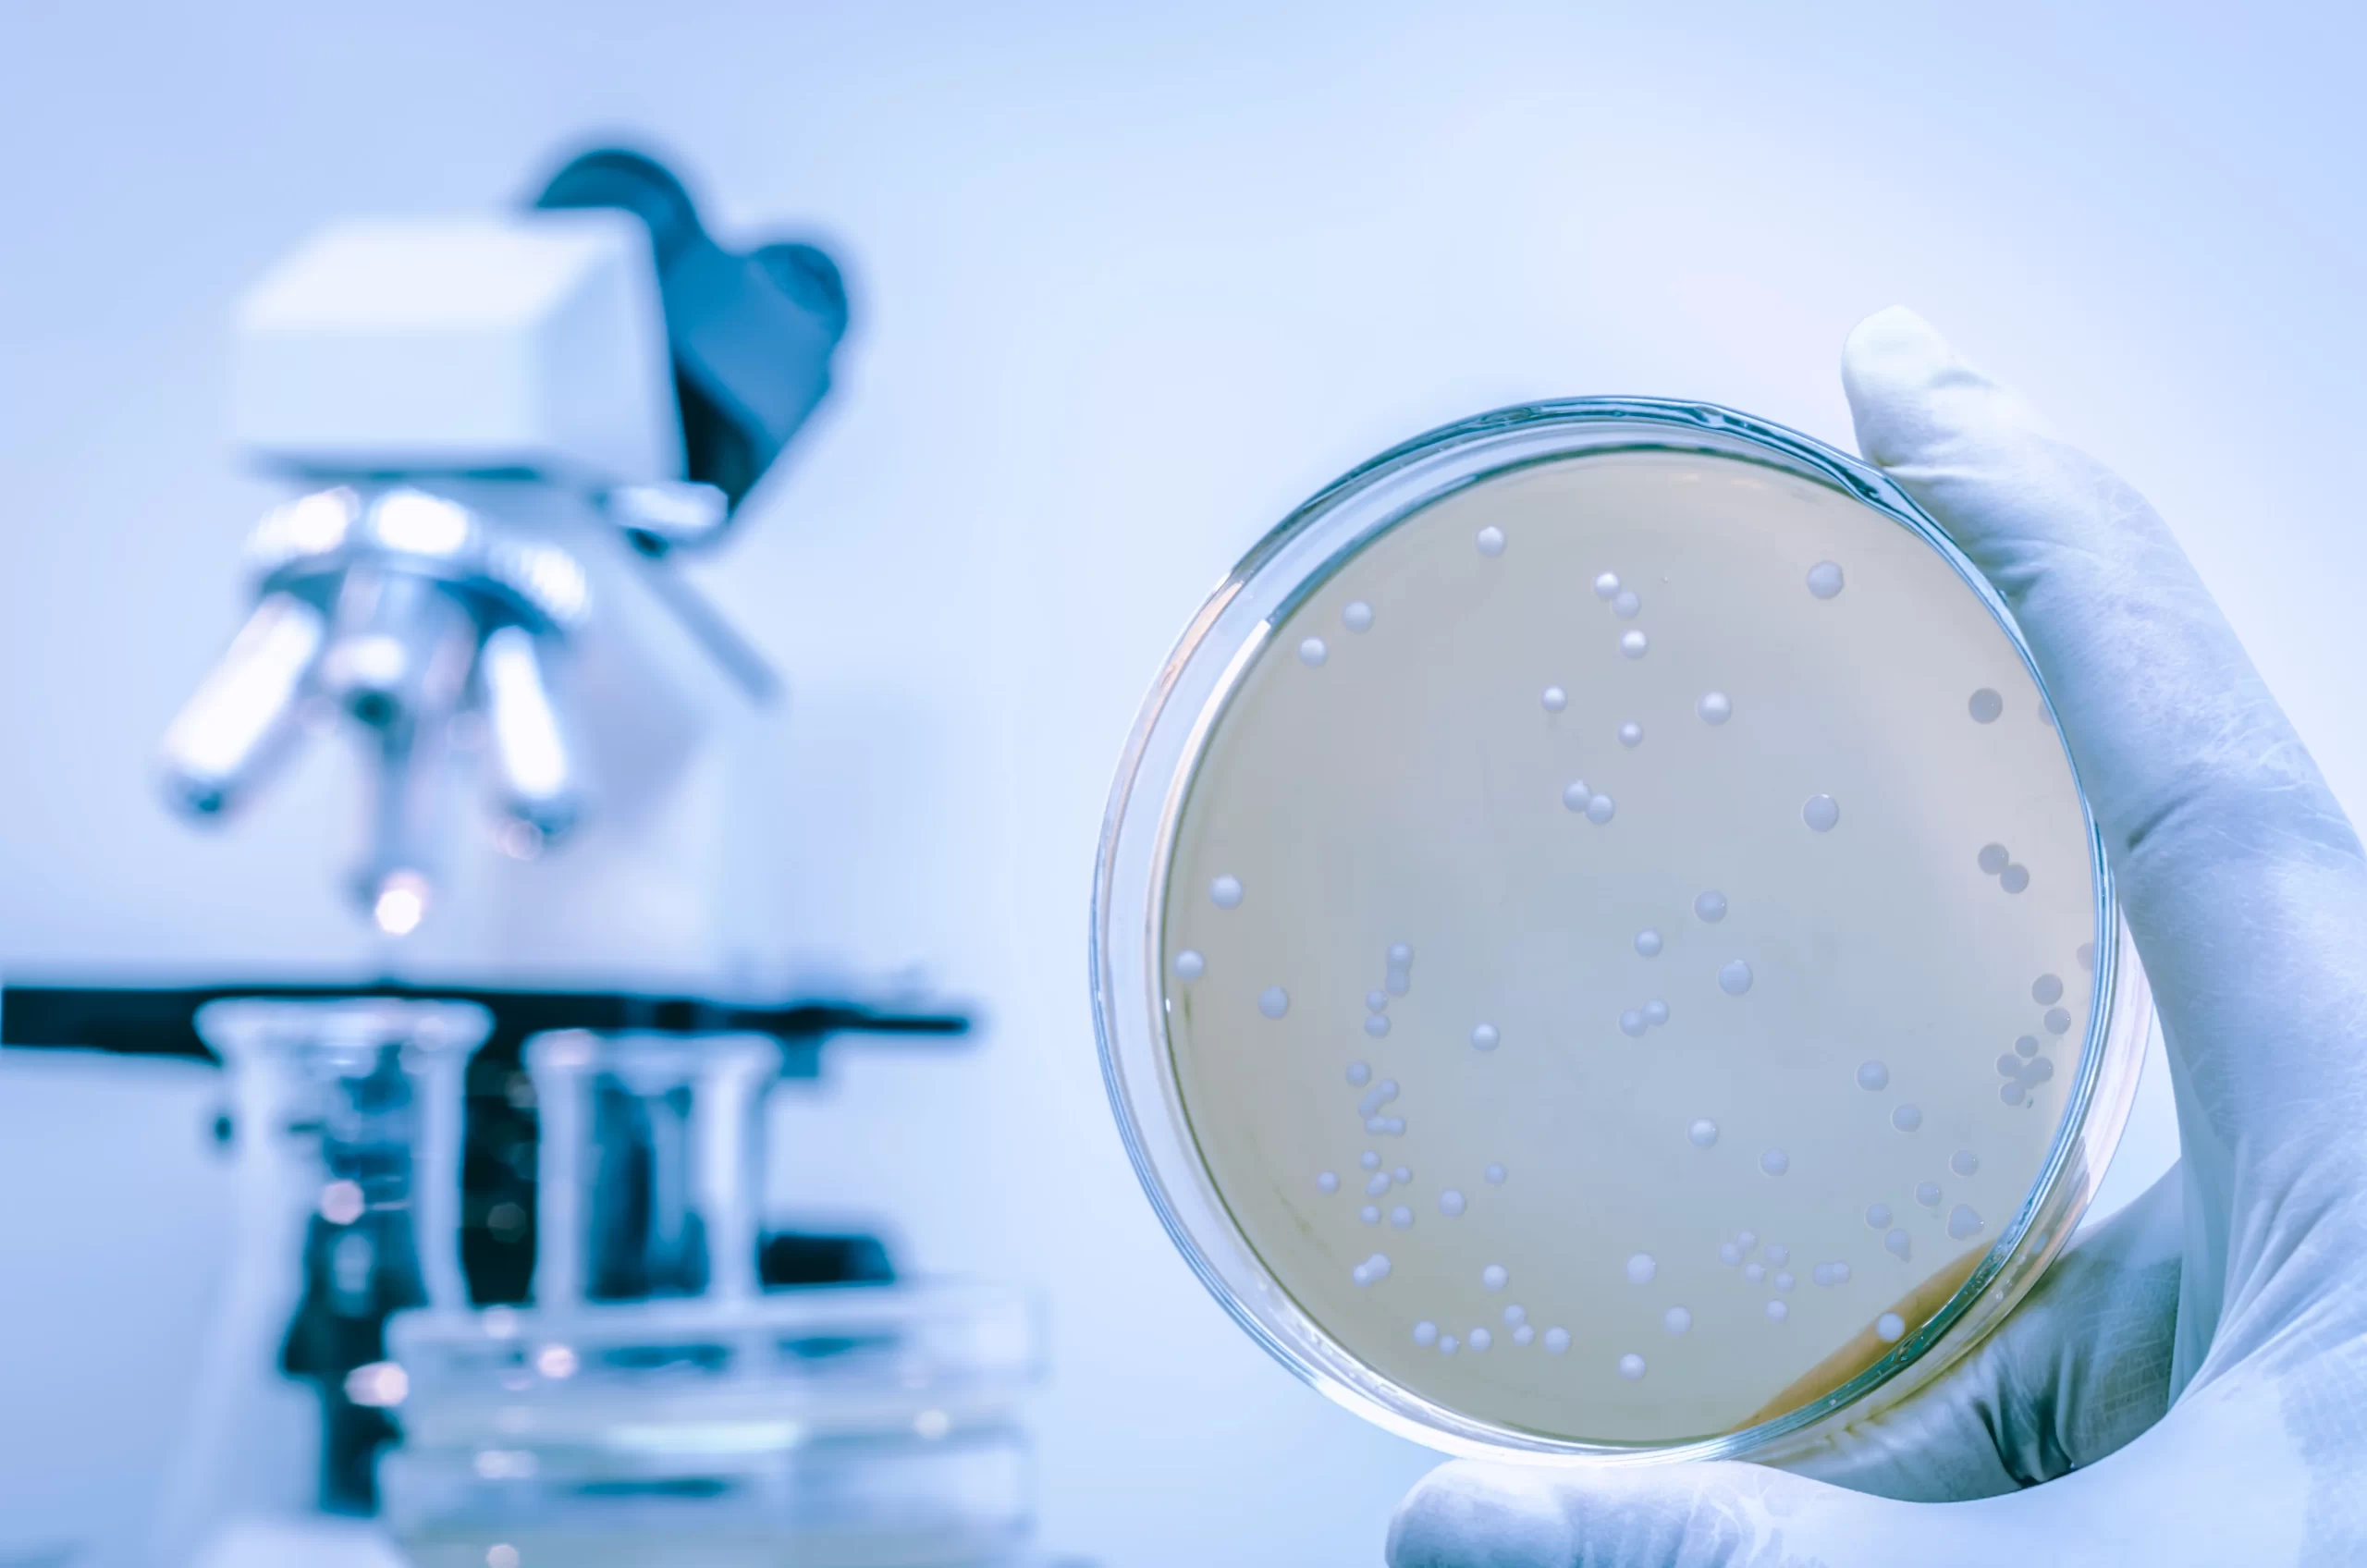

Description
Presentación:
Esta formación proporciona las herramientas y conocimientos necesarios para dar cumplimiento con el vigente Real Decreto 487/2022 de prevención y control de legionelosis. El personal de las instalaciones que realice tareas como: medición de biocida, temperatura y/o similares, deberá de tener la formación adecuada para hacerlo.
Dirigido a:
Personal indicado en el Real Decreto 487/2022 como encargado de realizar las operaciones menores en los protocolos de control de legionelosis. Extracto del RD 487/2022 Art. 18. Formación del personal: 3. El personal propio o de empresa de servicios a terceros que realice operaciones menores en la prevención y control de Legionella, en las instalaciones, tales como mediciones de temperatura, comprobación de los niveles de biocidas, control de pH, se incluirá dentro del plan de formación de la empresa titular de la instalación o de la empresa de servicios a terceros.
Duración: 1hora
Programa del curso:
Módulo 1: Formación Legionella
- Sección 1: Microbiología
Microorganismos, definición. - Sección 2: Legionella
Definición, historia, formas de infección y biología. - Sección 3: Real Decreto 487/2022
Normativa vigente: Formación personal, instalaciones, PPCL/PSL, muestreo, frecuencia. - Sección 4: Biocidas
Tipos de biocidas y diferentes registros - Sección 5: Medición operaciones menores
pH, Conductividad, Turbidez, Hierro, Temperatura
Módulo 2: Biocidas
Formación específica de los biocidas utilizados en las instalaciones.